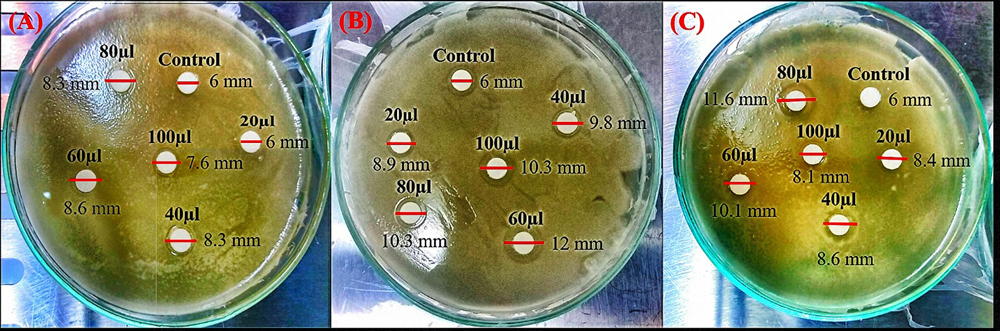

Location: Home >> Detail
TOTAL VIEWS
Med One. 2019;4:e190011. https://doi.org/10.20900/mo.20190011
1 Department of Chemical Engineering, Faculty of Engineering and Science, Curtin University, CDT 250, 98009 Miri, Sarawak, Malaysia
2 Chemical Engineering Department, University of Tennessee, Chattanooga, TN 37403, USA
* Correspondence: Jaison Jeevanandam, Tel.: +91-740-103-9626.
This article belongs to the Virtual Special Issue "Nanoparticles in Medicine"
Foodborne pathogens especially bacteria cause a vast number of diseases which leads to a high mortality rate in humans. Conventional antibiotics have been employed in an attempt to eradicate these pathogens and this has led to the evolution of a multidrug resistant bacteria strain. Thus, a new genre of antibiotics is prepared by using nanoparticles as they show effective antibacterial capabilities. Biosynthesized nanoparticles are less toxic to humans as compared to chemically synthesized nanoparticles which are prepared using toxic precursors. They also exhibit enhanced antibacterial action along with the biomolecules that help in their formation. Among most metal oxides, magnesium oxide (MgO) nanoparticles show unique antibacterial properties due to their exclusive oxide vacancies and crystalline structure. The antibacterial activity of MgO nanoparticles synthesized using leaf extract is further enhanced by the presence of phytochemicals. The present work is a comparative study of the antibacterial activity of MgO nanoparticles synthesized using three different leaf extracts: (1) Amaranthus tricolor, (2) Amaranthus blitum and (3) Andrographis paniculata and their reaction towards Escherichia coli which is a gram negative, food borne pathogen. The results showed that the ~78 nm spherical shaped MgO nanoparticles synthesized from A. blitum, exhibited the highest antibacterial activity at 60 μL dosage. In addition, the effects of the characteristics of the MgO nanoparticles such as size, morphology, concentration, surface charge and phytochemicals on antibacterial mechanism were also discussed.
In 2016, the World Health Organization (WHO) reported that 420,000 people died due to food borne diseases caused by several microbes and 125,000 among them were children below age of 5 years [1]. It is well known from previous reports that bacteria is the most important micro-organism which can spread lethal food-borne diseases [2,3]. Conventionally, antibiotics are extensively used to eradicate these disease-causing bactericides [4], which has led to the emergence of multidrug resistant bacterial strains in the long term [5,6]. Therefore, it is urgent to develop an enhanced antibacterial agent to deal with these multidrug resistant bacterial strains mediating the spread of food borne diseases. Recently, inorganic antibacterial agents have been studied extensively, due to their controlled reactive oxygen species (ROS) which suppresses the micro-organisms growth to effectively control pathogenic microorganisms [7–9]. It was reported that inorganic antibacterial agents showed improved safety and stability under high temperature treatments than organic antibiotics [10,11]. Inorganic nanoparticles, especially metal oxides are gaining attention in various industrial applications due to their ability to withstand harsh conditions [12,13], excellent antimicrobial activity [14,15] and they are highly useful in many biomedical applications such as tissue engineering, diagnostics and therapeutics [16,17]. Inorganic metal oxide nanoparticles such as ZnO [18], TiO2 [19], CuO [20] and MgO [21] have been widely studied as antibacterial agents. Among these particles, MgO nanoparticle is a unique metal oxide because it shows less toxicity towards hosts and compared to other metal oxide nanoparticles, it possesses various beneficial properties for biomedical applications including antibacterial activity [22,23].
Synthesis procedures play a significant role in attaining metal oxide nanoparticles with anticipated properties for a specific application [24,25]. There are various ways to synthesize metal oxide nanoparticles depending on the properties required for a particular application. Physical synthesis methods such as chemical vapor deposition [26], physical vapor deposition [27], laser ablation [28] and radio frequency magnetron sputtering [23,29] are commonly used in the metal oxide nanoparticle synthesis. Likewise, metal oxide nanoparticles are also prepared by chemical methods such as hydrothermal [30], wet-chemical [31], sol-gel [32], polyol [33] and microwave/ultrasound mediated chemical synthesis [34,35]. Both types of these synthesis methods have promising advantages, however, these synthesis methods involve expensive equipment and employ usage of hazardous chemicals which limits their application in the biomedical industry [36,37]. Thus, biosynthesis methods are preferred to synthesize nanoparticles for biomedical applications [38]. Three major biological organisms are involved in the biosynthetic nanoparticle preparation, namely bacteria [39], fungi [40] and plants [41]. Even though synthesis of nanoparticles via bacteria and fungi is potential for large scale nanoparticle synthesis with minimum usage of toxic chemicals [42–44], the extended production time is a stumbling block to its usage [45,46]. Hence, plant leaf extracts serves as an excellent medium to synthesize nanoparticle with controllable morphology and ability to enhance the downstream process of nanoparticle production [37]. There are only few reports available that supports the enhanced antibacterial activity of plant leaf extract mediated biosynthesized MgO nanoparticles [47–49]. Thus, the aim of the present work is to compare the antibacterial activity of MgO nanoparticles synthesized by three different leaf extracts towards gram-negative E. coli bacteria. The effects of nanoparticle characteristics such as size, morphology, concentration, surface charge and phytochemicals in influencing the antibacterial activity of MgO nanoparticles are also discussed.
The MgO nanoparticles were synthesized by using plant extracts namely Amaranthus tricolor, Amaranthus blitum and Andrographis paniculata. The aqueous plant extracts were prepared by adding fresh leaves of each plant, individually, with distilled water in the ration 1:10. The extracts were prepared by heating the mixture at 100 °C for 20 min and constantly mixing at 350 rpm via magnetic stirrer (Cole-Parmer, Mumbai, India). Finally, the extracts were obtained by filtration using Whatman No. 1 filter paper to remove impurities and the pure extracts were stored at 4 °C in refrigerator for further use. The synthesis parameters were optimized and the nanoparticles were characterized using Dynamic light scattering (DLS) technique (Malvern, Singapore), UV-visible spectrometer (Perkin Elmer, Selangor, Malaysia), Fourier transform infrared (FTIR) spectroscopy (Mettler Toledo, Singapore) and Transmission electron microscopy (TEM) (Hitachi, Kuala Lumpur, Malaysia) to confirm their physicochemical characters such as size, surface charge, functional groups and morphology as reported in our previous study [50,51]. The physicochemical characteristics of MgO nanoparticles prepared from three distinct leaf extracts are shown in Table 1.
 Table 1. Characteristics of leaf extract mediated biosynthesized MgO nanoparticles (Adapted and reproduced from [50] with permission from The Royal Society of Chemistry).
Table 1. Characteristics of leaf extract mediated biosynthesized MgO nanoparticles (Adapted and reproduced from [50] with permission from The Royal Society of Chemistry).
The microorganism Escherichia coli (MTCC739) was obtained from Sigma-Aldrich (Selangor, Malaysia). In the present study, this strain was used to evaluate the inhibition ability of nanoparticles, as it is highly stable towards heavy metals compared to other strains. Most of the previously reported studies utilized this strain to evaluate the antibacterial activity of natural extracts against food borne pathogens [52,53]. In addition, it is noteworthy that the inhibition of this E. coli strain by a naturally extracted material demonstrates the capacity of the extract to inhibit growth of most E. coli stains [54,55]. The purchased bacterial cells were stored in a refrigerator at −2 °C. 2.1% w/v of Mueller-Hinton broth purchased from Merck (Selangor, Malaysia) was dissolved in 50 mL of distilled water and was autoclaved at 121 °C for 15 min. The bacterial cells were thawed at 25 °C and 1% v/v of bacteria was inoculated into the autoclaved broth under sterile condition. The broth with bacterial inoculum was incubated in a rotary shaking incubator for 30 hours at 30 °C with 200 rpm.
Antibacterial ActivityThe fully-grown bacterial cells in the broth medium were harvested by centrifugation at 25 °C, 3500 rpm for 5 min. The supernatant was removed, and the cell pellet was washed for several times with distilled water. The bacteria was then transferred to Mueller-Hinton agar procured from Merck using spread plate technique [56]. The colloidal MgO nanoparticles were diluted with distilled water to analyze the effect of the concentration and dosage of the nanoparticles in inhibiting bacterial growth. Different dosages of MgO nanoparticles from three different leaf extracts were transferred to a sterile disc placed on the agar plate cultured with E. coli and the zone of inhibitions were measured after incubation at 30 °C for 30 hours.
Concentration and Dosage of Biosynthesized MgO NanoparticlesSince the MgO nanoparticles were synthesized by using different leaf extracts which possess distinct phytochemical compositions, the concentration of nanoparticles per unit volume varies from one to another. The concentration of MgO nanoparticles synthesized by leaf extracts were calculated using standard linear graph method (Origin 8 software). Spherical shaped chemically synthesized MgO nanoparticles [57] were used to obtain the MgO linear correlation graph. The linear equation Y = 0.3748x + 0.0511 was obtained as the line of best fit from the graph displayed in Figure 1. The concentration and quantity of MgO nanoparticles prepared using leaf mediated biosynthesis method can be attained by substituting the respective absorbance at 322 nm in the linear equation. The concentration and quantity of MgO nanoparticle prepared by each leaf extract are listed in Table 2. Dosages ranging from 20 to 100 μL of colloidal MgO nanoparticles were used in the study.
The concentration of MgO nanoparticle present in each dosage which was prepared by using the three distinct leaf extracts as tabulated in Table 3. The yield of the nanoparticles depends on the crude phytochemicals extracted from the plants and this study aims at evaluating the antibacterial efficiency of crude phytochemical coated MgO nanoparticles. The dosages used in the study are reported as μL to compare the antibacterial activity of MgO nanoparticles from three different plant extracts which yields different concentration of MgO nanoparticles as mentioned in literature [58,59]. Thus, it is essential to note the concentration of nanoparticles present in each dosage of the samples as denoted in Table 3.
Antibacterial Activity of MgO NanoparticlesFigure 2A–C shows the antibacterial activity of MgO nanoparticles prepared using three different leaf extracts at different dosages (20–100 μL) against a foodborne gram negative pathogen E. coli. It is evident as shown in Figure 2 that MgO nanoparticles possess antibacterial activity against E. coli based on the zone of inhibition. However, the zone of inhibition was found to be less compared to other literatures, the concentration of nanoparticles synthesized by using aqueous leaf extract were low [47,48,60–62]. Literature shows that chemically synthesized MgO nanoparticle at higher concentration (<100 μg/mL) exhibits strong antibacterial activity against food borne bacteria [60–62]. On the other hand, biosynthesized MgO nanoparticle activity against food borne bacteria were also reported in some literatures [47–49] to have a higher bacterial inhibiting concentration compared to the present work. The current result shows that the colloidal MgO nanoparticles exhibited a linear concentration related antibacterial activity rather than dosage related antibacterial effect. The zone of inhibition is lower than the previous reports as the concentration used in the present work was much lower than mentioned in the literatures and as colloidal MgO nanoparticles were used against the bacterial strains. It can be observed that there is no linear relation between dosage and antibacterial activity of MgO nanoparticles as depicted by the zone of inhibition measured in Figure 2. Sample NT and NB show concentration related increase in antibacterial activity of MgO nanoparticle up to 60 μL dose whereas sample NP shows dosage dependent increase of antibacterial activity up to 80 μL dosage. Subsequently, we observe a decrease in the zone of inhibition indicating a lower antibacterial activity at higher dosages. This may be due to bacteria resistance against a higher concentration of nanoparticles [63]. This may also be due to agglomeration when a higher concentration (dosage) of nanoparticles are added to the bacterial growth medium which then reduces the release of ROS that goes on to induce bacterial cell death and prevent their growth. Also noteworthy is that the zone of inhibition of sample NB at 60 μL dosage towards E. coli is similar to the previous work in which 5 mg/mL of Aloe vera extract synthesized MgO nanoparticles were used [47]. However, 60 μL dosage contains 64.8 μg/mL of MgO nanoparticles which is lower than the amount of nanoparticles used to inhibit bacteria in the previous work. Similarly, 100 μg/mL of rod shaped MgO nanoparticles synthesized via A. paniculata leaf extract showed enhanced zone of inhibition towards E. coli (20 mm) [48]. However, the present work shows that there is a higher antibacterial activity against E. coli for MgO nanoparticles synthesized via A. paniculata leaf extract at 80 μL dosage (11.6 mm) which contains only ~65 μg/mL of MgO nanoparticle.
Figure 2. Representative images of three experiments for each sample: Zone of E. coli inhibition observed after treating with (A) sample NT, (B) sample NB and (C) sample NP. Sample NT—MgO nanoparticles prepared using magnesium nitrate and A. tricolor leaf extract, Sample NB—MgO nanoparticles prepared using magnesium nitrate and A. blitum leaf extract, Sample NP—MgO nanoparticles prepared using magnesium nitrate and A. paniculata leaf extract. The colloidal MgO nanoparticles were diluted with distilled water to analyze their antibacterial effect. Different dosages of three MgO nanoparticle samples were transferred to a sterile disc placed on the agar plate cultured with E. coli and the zone of inhibitions were measured after incubation at 30 °C for 30 hours. Experiments were conducted in triplicate (n = 3).
Figure 2. Representative images of three experiments for each sample: Zone of E. coli inhibition observed after treating with (A) sample NT, (B) sample NB and (C) sample NP. Sample NT—MgO nanoparticles prepared using magnesium nitrate and A. tricolor leaf extract, Sample NB—MgO nanoparticles prepared using magnesium nitrate and A. blitum leaf extract, Sample NP—MgO nanoparticles prepared using magnesium nitrate and A. paniculata leaf extract. The colloidal MgO nanoparticles were diluted with distilled water to analyze their antibacterial effect. Different dosages of three MgO nanoparticle samples were transferred to a sterile disc placed on the agar plate cultured with E. coli and the zone of inhibitions were measured after incubation at 30 °C for 30 hours. Experiments were conducted in triplicate (n = 3).
Figure 3 shows the antibacterial activity of MgO nanoparticles prepared in sample NT, NB and NP. It can be noted that both sample NB and NT showed better antibacterial activity at 60 μL dosage, compared to sample NP. However, sample NB shows higher zone of inhibition (12 mm) at 60 μL dosage compared to all the samples. Sample NP shows a distinct mechanism of antibacterial activity compared to other two samples and the highest zone of inhibition was found to be at 80 μL dosage. This difference in the antibacterial mechanism may be due to the quantity of phytochemicals present in the leaf extract [38] or the nanoparticle concentration from leaf extract mediated synthesis [64]. It has been explained in literature that phytochemicals serve as the reducing and stabilizing agent for nanoparticle synthesis [38]. Thus, these phytochemicals are responsible for nanoparticle concentration in the colloidal solution [64] which is significant in the current study. Depending on the concentration, shape and size in each dosage, MgO nanoparticles exhibited dosage dependent antibacterial activity against E. coli bacteria. Also, it can be observed that the quantity of phytochemicals present in each of the leaf is different [65–72] and certain phytochemicals such as flavonoids, phenols and terpenoids possess antibacterial activity [73–75] which also contribute to the overall antibacterial mechanism of these biosynthesized MgO nanoparticles.
 Figure 3. Comparative antibacterial activity of sample NT, NB and NP via disc diffusion method. Sample NT—MgO nanoparticles prepared using magnesium nitrate and A. tricolor leaf extract, Sample NB—MgO nanoparticles prepared using magnesium nitrate and A. blitum leaf extract, Sample NP—MgO nanoparticles prepared using magnesium nitrate and A. paniculata leaf extract. Experiments were conducted in triplicate (n = 3), and the error bars represent the standard deviation. Both sample NB and NT showed better antibacterial activity at 60 μL dosage, compared to sample NP.
Figure 3. Comparative antibacterial activity of sample NT, NB and NP via disc diffusion method. Sample NT—MgO nanoparticles prepared using magnesium nitrate and A. tricolor leaf extract, Sample NB—MgO nanoparticles prepared using magnesium nitrate and A. blitum leaf extract, Sample NP—MgO nanoparticles prepared using magnesium nitrate and A. paniculata leaf extract. Experiments were conducted in triplicate (n = 3), and the error bars represent the standard deviation. Both sample NB and NT showed better antibacterial activity at 60 μL dosage, compared to sample NP.
The novelty of this current study is in the utilization of heat energy catalyzed, aqueous leaf extract for the synthesis of MgO nanoparticles in the antibacterial activity against E. coli. The magnesium nitrate was used as the precursor for the synthesis of nanoparticles which also enhances the synthesis process due to their lower molecular mass compared to other reported precursors such as magnesium acetate and magnesium nitrate along with sodium hydroxide [50,76]. Since it is a heat based catalyzed process, phytochemicals present may be degraded and lead to a difference in the quantity of nanoparticle produced in the different MgO samples [77] as in the current study.
Antibacterial activity of metal oxide nanoparticles can be attributed to three major mechanisms namely disruption of cell wall via electrostatic attraction [78], generation of reactive oxygen species (ROS) [79] and disruption of cell organelles, nucleus or genetic material [80]. It can be noted that phytochemicals which act as a reducing and stabilizing agent for MgO nanoparticle also have the potential of inhibiting bacterial growth [81]. Based on the previous reports and current results, three possible antibacterial mechanisms of MgO nanoparticles have been postulated in this study as shown in Figure 4. Figure 4 is a conceptual representation of probable antibacterial mechanism of MgO nanoparticles based on literatures and no evidence has been provided in the present manuscript to support it. Mechanism 1 explains the degradation of MgO nanoparticles by extracellular bacterial enzymes thereby facilitating the release of ROS. Bacteria possess a tendency of reducing complex molecules into simple ions as a source of nutrients for its growth and reproduction [82]. The bacteria may release extracellular enzymes which reduces MgO nanoparticles into ions along with the phytochemicals which stabilizes the nanoparticles [83]. The reduced phytochemicals from nanoparticles also may possess certain level of antibacterial activity through ROS production [84]. Moreover, it is noteworthy from the literatures that most of the phytochemicals present in each leaf extract possess antibacterial activity. These phytochemicals include phenols, flavonoids, saponins, alkaloids, carotenoids, andrographolides, tannin and anthocyanidin, which may also contribute towards the antimicrobial activity of the MgO nanoparticles [77,85–87]. Along with phytochemicals, the oxygen ion released from MgO nanoparticle also leads to ROS production [88]. The magnesium ion released from the nanoparticle binds and enters into the bacterial cell via electrostatic attraction which damages bacterial cell membrane by reaction with sulfhydryl group [79,89]. The ROS production by oxygen ion, reduced phytochemicals and magnesium ion reaction with sulfhydryl group leads to the antibacterial activity of MgO nanoparticle according to mechanism 1 in Figure 4.
 Figure 4. Proposed antibacterial mechanisms of MgO nanoparticles synthesized using heat catalyzed leaf extracts. Mechanism-1: Degradation of MgO nanoparticles by extracellular bacterial enzymes and facilitates the release of ROS; Mechanism-2: Binding of MgO nanoparticle with bacterial cell wall through electrostatic attraction and follows mechanism-1; and Mechanism-3: Entry of MgO nanoparticle into bacterial cells, reduces into ions via intracellular bacterial enzymes, causes mortality to bacterial population and follows ROS production similar to mechanism 1.
Figure 4. Proposed antibacterial mechanisms of MgO nanoparticles synthesized using heat catalyzed leaf extracts. Mechanism-1: Degradation of MgO nanoparticles by extracellular bacterial enzymes and facilitates the release of ROS; Mechanism-2: Binding of MgO nanoparticle with bacterial cell wall through electrostatic attraction and follows mechanism-1; and Mechanism-3: Entry of MgO nanoparticle into bacterial cells, reduces into ions via intracellular bacterial enzymes, causes mortality to bacterial population and follows ROS production similar to mechanism 1.
On the other hand, the mechanism 2 in Figure 4 explains the binding of MgO nanoparticle with bacterial cell wall through electrostatic attraction [90] and follows the mechanism as stated in mechanism 1. The probability of this antibacterial mechanism for MgO nanoparticle is low as the surface charge of both nanoparticles as shown in Table 1 [50] and cell surface are negative [91]. Mechanism 3 in Figure 4 explains the entry of MgO nanoparticle into bacterial cell [92], reduced into ions via intracellular bacterial enzymes and causes mortality to bacterial population [93] following ROS production similar to mechanism 1. This mechanism may also be possible as the pore size of bacterial cell wall ranges in between 50-500 nm [94] while those of the MgO nanoparticles used in the current studies are between 30–80 nm size [77]. However, it was speculated that mechanism 1 may be the reason for antibacterial activity in the current study. This is because as the dosage increased, the antibacterial activity revealed that the extracellular bacterial enzymes slowly degraded the phytochemical stabilized MgO nanoparticles. The higher antibacterial activity at 60 μL dosage of sample NT, NB and 80 μL dosage of sample NP may be due to the effect of extracellular enzyme activity in degrading the nanoparticle and the phytochemicals that stabilizes the nanoparticles. However, the exact mechanism of leaf extract synthesized MgO nanoparticles is still unknown and will be explored by further studies against several foodborne pathogens. 2′-7′-Dichlorodihydrofluorescein diacetate (DCFH-DA) is a cell permeable fluorescent and chemiluminescent probe widely available for direct measurement of cellular redox state [95]. Other methods such as high performance liquid chromatography [96], capillary electrophoresis [97], luciferin derivative in conjunction with glutathione S-transferase enzyme and bimane compounds such as monobromobimane and monochlorobimane [98] were used to measure reduced glutathione and oxidized reduced glutathione levels in cells which indicate cellular oxidative stress via presence of reactive oxygen species [99].
The present study reveals the antibacterial activity of MgO nanoparticles synthesized by using three different leaf extracts. It can be noted that MgO nanoparticles sample from A. blitum leaf extract shows higher antibacterial activity towards E. coli at 60 μL/mL dosage. The concentration and dosage of MgO nanoparticles present in each sample was identified by using linear graph obtained by different concentration of chemically synthesized pure MgO nanoparticles. A comparison of the antibacterial activity of different leaf extract synthesized MgO nanoparticles were also carried out. Further experimental validation of the antimicrobial activity of MgO nanoparticles with phytochemicals as functional groups may involve the comparison of chemically synthesized MgO nanoparticles, purified MgO nanoparticles and leaf extract as a control. A conceptual antimicrobial mechanism of the MgO nanoparticles is also discussed. The proposed mechanism is based on the findings from the disc diffusion method of the present work and reported literature. Microscopic analysis to evaluate the antibacterial mechanism of MgO nanoparticles, mass spectroscopic analysis of the phytochemical-MgO nanoparticles to evaluate the functional moieties and flowcytometry analysis to evaluate the ROS produced by the nanoparticles will further validate the preliminary findings of this work. The current study will promote research into the antibacterial activity of MgO nanoparticles via leaf extract mediated synthesis and enable related applications as a potential antibacterial agent to control food borne pathogens.
The dataset of the study is available from the authors upon reasonable request.
JJ designed and performed the study. YSC analyzed the data and wrote the paper. MKD reviewed the manuscript and enhanced the discussion section.
The authors declare that there is no conflict of interest.
No fund was received for this project.
The authors wish to acknowledge Curtin University, Malaysia, for their financial support through the Curtin Sarawak Postgraduate Research Scholarship (CSPRS) scheme.
1.
2.
3.
4.
5.
6.
7.
8.
9.
10.
11.
12.
13.
14.
15.
16.
17.
18.
19.
20.
21.
22.
23.
24.
25.
26.
27.
28.
29.
30.
31.
32.
33.
34.
35.
36.
37.
38.
39.
40.
41.
42.
43.
44.
45.
46.
47.
48.
49.
50.
51.
52.
53.
54.
55.
56.
57.
58.
59.
60.
61.
62.
63.
64.
65.
66.
67.
68.
69.
70.
71.
72.
73.
74.
75.
76.
77.
78.
79.
80.
81.
82.
83.
84.
85.
86.
87.
88.
89.
90.
91.
92.
93.
94.
95.
96.
97.
98.
99.
Jeevanandam J, Chan YS, Danquah MK. Evaluating the Antibacterial Activity of MgO Nanoparticles Synthesized from Aqueous Leaf Extract. Med One. 2019;4:e190011. https://doi.org/10.20900/mo.20190011

Copyright © 2020 Hapres Co., Ltd. Privacy Policy | Terms and Conditions